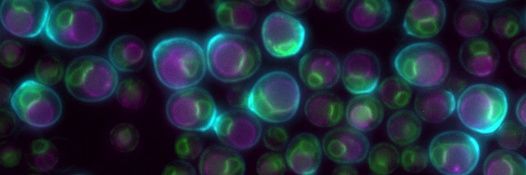
BüttnerLab banner

Angehefteter Tweet

We are so happy to share our latest story led by Simon Prokisch (@KirschePro): "Partitioning into ER membrane microdomains impacts autophagic protein turnover during cellular aging". nature.com/articles/s4159…
English
BüttnerLab
629 posts

@ButtnerLab
We are yeast and fly enthusiasts interested in different aspects of cellular aging and organellar connectivity. Account run by lab members.























New preprint w/ @apsarruda! Tour de force from grad student extraordinaire @alymathiowetz! >20 CRISPR screens enabled the discovery of a key role for CLCC1 in hepatic neutral lipid flux and nuclear pore complex assembly. Many surprises! #LipidDroplets 1/3 biorxiv.org/content/10.110…

